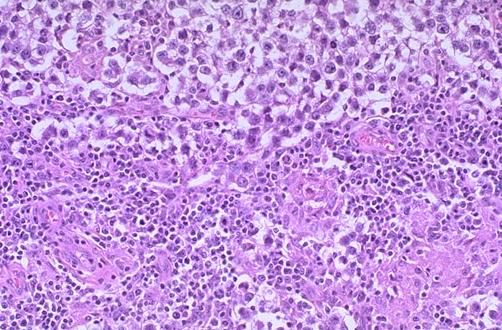

参考教材
参考教材,注意j9集团的版权:仅限加入本模块学习的同学下载使用,请勿转发,更勿商用。一经发现,责任自负。
俞小瑞主编,本科整合教材,人民卫生出版社,2015年
徐长福,魏强主编,本科整合教材_人民卫生出版社,2015年
陈江华主编,本科整合教材_人民卫生出版社,2015年
李旭,徐丛剑主编_本科整合教材_,人民卫生出版社,2015年
李和,黄辰主编,本科整合教材_人民卫生出版社,2015年
邹仲之,李继承。人民卫生出版社,2013
longman'smedical embryology
elsevier's integrated histology
gray’s anatomy for students, 3rd edition
[奈特病理学彩色图谱].崔全才2008译
病理学(第四版)(密码:www.thiseye.net)
杨岚主编. 本科整合教材 ,人民卫生出版社,2015年
病理学彩色图谱(密码:www.thiseye.net)
病理生理学(第四版)(密码:www.thiseye.net)
anatomy and physiology 8th ed. - r. seeley, et. al., (mcgraw-hill, 2008) ww
diagnostic medical sonography - obstetrics - gynecology
obstetric and gynecologic ultrasound - case review series_ 2nd ed